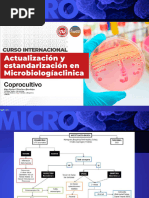

0% encontró este documento útil (0 votos)
44 vistas54 páginasTPT 3HP y 1HP Ecuador
El documento presenta el Tratamiento Preventivo de la Tuberculosis (TPT), destacando los esquemas 3HP y 1HP, y su importancia en la reducción del riesgo de progresión a enfermedad tuberculosa en personas con alto riesgo. Se discuten evidencias sobre la eficacia de estos tratamientos, recomendaciones de la OMS y experiencias locales, enfatizando la necesidad de aumentar su uso en poblaciones vulnerables, especialmente en personas viviendo con VIH. Además, se abordan las preocupaciones sobre la adherencia y la resistencia a los medicamentos en el contexto del TPT.
Cargado por
esmeraldafuertes47Derechos de autor
© © All Rights Reserved
Nos tomamos en serio los derechos de los contenidos. Si sospechas que se trata de tu contenido, reclámalo aquí.
Formatos disponibles
Descarga como PDF, TXT o lee en línea desde Scribd
0% encontró este documento útil (0 votos)
44 vistas54 páginasTPT 3HP y 1HP Ecuador
El documento presenta el Tratamiento Preventivo de la Tuberculosis (TPT), destacando los esquemas 3HP y 1HP, y su importancia en la reducción del riesgo de progresión a enfermedad tuberculosa en personas con alto riesgo. Se discuten evidencias sobre la eficacia de estos tratamientos, recomendaciones de la OMS y experiencias locales, enfatizando la necesidad de aumentar su uso en poblaciones vulnerables, especialmente en personas viviendo con VIH. Además, se abordan las preocupaciones sobre la adherencia y la resistencia a los medicamentos en el contexto del TPT.
Cargado por
esmeraldafuertes47Derechos de autor
© © All Rights Reserved
Nos tomamos en serio los derechos de los contenidos. Si sospechas que se trata de tu contenido, reclámalo aquí.
Formatos disponibles
Descarga como PDF, TXT o lee en línea desde Scribd